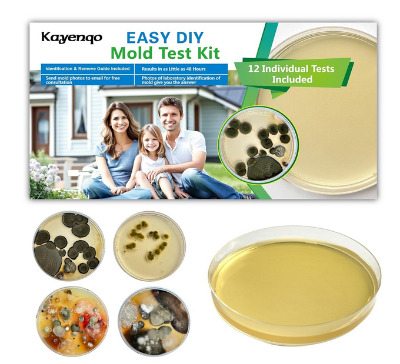
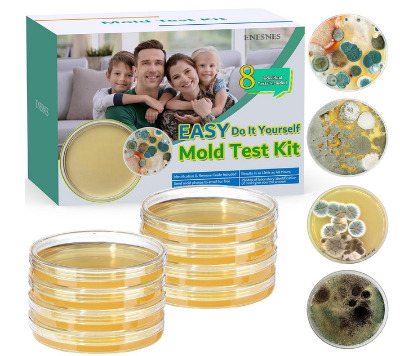
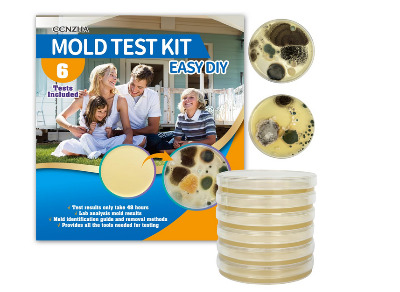

5 Best At Home Mold Test Kits In 2026
Mold growth in your home can trigger serious health problems and damage your property. Many homeowners struggle to identify hidden mold colonies lurking behind walls, in HVAC systems, or on various surfaces. Professional mold inspection services often cost hundreds of dollars, making them inaccessible for routine checks.
At-home mold test kits offer an affordable solution for detecting mold spores before they become a major issue. These DIY testing products allow you to collect samples from different areas of your home and either analyze them yourself or send them to certified laboratories for detailed results.
This comprehensive guide examines the top-rated mold detection kits available on the market. We tested multiple products to help you find the right solution for your indoor air quality concerns. Each kit varies in the number of tests provided, analysis methods, and features included.
Why You Need a Mold Test Kit
Indoor mold exposure can cause respiratory issues, allergic reactions, and other health complications. People with asthma, allergies, or compromised immune systems face higher risks when living in mold-contaminated environments. Children and elderly family members are particularly vulnerable to mold-related health effects.
Visible mold growth represents only part of the problem. Mold spores travel through the air and settle in places you cannot easily see. Your HVAC system can distribute these microscopic particles throughout your entire home. Testing helps you identify problem areas before they escalate into costly remediation projects.
Musty odors often indicate hidden mold growth, but you need proper testing to confirm the presence and type of mold species. Different mold varieties require different removal approaches. Black mold, for instance, poses more serious health risks than other common household molds.
Regular testing helps you maintain a healthy living environment. After experiencing water damage, flooding, or persistent humidity issues, testing becomes even more critical. These kits empower you to take control of your indoor air quality without waiting for obvious symptoms to appear.
How Home Mold Test Kits Work
Most at-home mold testing kits use similar collection methods. You expose a collection plate or swab to the air or surface you want to test. The kit captures mold spores present in your environment during the exposure period.
Some kits provide instant results through color-changing indicators or visible spore growth patterns. These self-analysis options give you quick answers about mold presence. However, they typically cannot identify specific mold species or concentration levels.
Laboratory analysis offers more detailed information about your samples. You collect specimens according to kit instructions, then mail them to a certified testing facility. Lab technicians examine your samples using advanced microscopy and culturing techniques. They identify mold species and provide concentration data in their reports.
The testing process usually takes between 48 hours and two weeks, depending on the kit type and analysis method. Self-testing kits deliver faster results but with less specificity. Lab-analyzed kits take longer but provide comprehensive data about the mold types in your home.
Top 5 Home Mold Test Kits Reviewed
1. Premium 12-Test Mold Detection Kit for Comprehensive Home Analysis
This extensive testing kit stands out with twelve individual tests, making it ideal for larger homes or thorough property assessments. The kit targets multiple testing scenarios including HVAC systems, various surfaces, and general air quality monitoring.
Product Description
The 12-test kit provides everything needed for comprehensive mold detection across your entire property. Each test comes individually packaged to maintain sterility and accuracy. The included identification guide helps you understand your results and take appropriate action based on findings.
Key Features
- Twelve separate testing plates for extensive coverage
- Pre-labeled collection media for easy organization
- Step-by-step visual instructions
- Detailed mold identification reference guide
- Tests multiple surface types and air samples
- HVAC system testing capabilities
- Non-toxic and safe for household use
- Results visible within 48 hours
- Reusable storage containers included
How to Use
Open each test plate in the area you want to monitor. Expose the collection medium to air for the recommended duration or swab surfaces according to instructions. Close the plates and place them in a warm, dark location. Check the plates after two days to observe any mold growth patterns.
Pros
- Exceptional value with twelve tests per kit
- Covers extensive areas of your home
- Simple enough for first-time users
- Quick results without lab wait times
- Comprehensive identification guide included
- Tests both air and surface mold
- Ideal for large homes or multi-room testing
- Clear instructions reduce user error
Cons
- Results require some interpretation skills
- Cannot identify specific mold species
- May need laboratory confirmation for serious infestations
- Requires proper storage conditions for accuracy
Best For
This kit works perfectly for homeowners who want to test multiple rooms, levels, or areas of concern. The twelve tests allow you to monitor your entire property or track mold levels over time. It suits people who prefer immediate results over detailed laboratory analysis.
2. Professional 8-Test Kit with Free Laboratory Analysis
This eight-test kit combines DIY convenience with professional laboratory expertise. Each test includes free lab analysis, giving you both quick visual results and detailed scientific reports about your home’s mold situation.
Product Description
The kit bridges the gap between self-testing and professional inspection services. You collect samples at home using the provided materials, then send them to a certified laboratory for thorough analysis. The lab examines your samples and delivers a comprehensive report identifying mold species and concentration levels.
Key Features
- Eight individual test units
- Free laboratory analysis for each sample
- Prepaid return shipping labels
- Tests HVAC systems, surfaces, and air quality
- Certified laboratory results
- Detailed identification guide for immediate reference
- Professional reporting within 7-10 business days
- Black mold detection capabilities
- Clear sampling instructions
How to Use
Expose collection plates in your chosen locations following the timing guidelines provided. For surface testing, use the included swabs to collect samples from suspicious areas. Seal your samples in the provided containers and mail them using the prepaid shipping label. Wait for your laboratory results to arrive via email or mail.
Pros
- Combines DIY testing with professional analysis
- Free lab services add tremendous value
- Identifies specific mold species accurately
- Professional reports provide actionable recommendations
- Prepaid shipping eliminates extra costs
- Eight tests cover multiple rooms or concerns
- Black mold specifically identified
- No hidden laboratory fees
Cons
- Results take longer than self-analysis kits
- Requires mailing samples to laboratory
- Need to wait 1-2 weeks for complete results
- More expensive than basic testing kits
Best For
Homeowners who suspect serious mold problems benefit most from this kit. The professional laboratory analysis provides definitive answers about mold species and health risks. It works well when you need documentation for landlords, home sales, or insurance claims.
3. Comprehensive 7-Test Mold Detection System
This seven-test kit offers balanced coverage for average-sized homes. It focuses on the most common mold testing scenarios while remaining affordable and user-friendly. The kit specifically targets black mold detection along with other common household mold varieties.
Product Description
The seven-test system provides focused testing for critical areas where mold typically develops. Each test plate comes ready to use with clear labeling and instructions. The included identification guide features color photographs of common mold types to help you interpret your results.
Key Features
- Seven individually sealed test plates
- Specialized black mold detection
- HVAC system testing components
- Surface and air quality testing options
- Detailed photographic identification guide
- Color-coded collection media
- Temperature indicator strips
- Results appear within 48-72 hours
- Compact storage case
How to Use
Select seven strategic locations throughout your home, focusing on areas with moisture, poor ventilation, or musty odors. Open test plates and expose them according to the timing chart provided. For HVAC testing, place plates near return vents during system operation. Incubate sealed plates in a warm area and observe growth patterns after the recommended waiting period.
Pros
- Seven tests handle most residential needs
- Affordable pricing point
- Specific black mold detection features
- User-friendly design for beginners
- Quick result turnaround
- Photographic guide aids identification
- Compact kit easy to store
- No complicated procedures
Cons
- Fewer tests than larger kits
- Self-interpretation may lack precision
- No laboratory analysis included
- May need multiple kits for large homes
Best For
This kit serves homeowners seeking a middle-ground solution between basic and extensive testing. Seven tests adequately cover typical homes while keeping costs reasonable. It suits people who want quick answers without the expense of professional laboratory services.
4. Advanced 6-Test Kit with Lab Analysis and Fast Results
This six-test kit emphasizes speed and reliability. It includes free laboratory analysis for each sample while maintaining a streamlined testing process. The kit focuses on delivering accurate, professionally verified results in the shortest time possible.
Product Description
The advanced testing system combines efficient sampling methods with express laboratory services. Each test uses improved collection media that captures mold spores more effectively. The laboratory partner prioritizes these samples for faster processing times without compromising accuracy.
Key Features
- Six individual testing components
- Free express laboratory analysis
- Faster lab turnaround than standard kits
- Black mold detector technology
- Indoor air quality assessment tools
- Detailed identification guide included
- Priority processing at certified labs
- Professional mold reports
- Easy-to-understand result formats
How to Use
Deploy test plates in areas of concern throughout your home. Follow exposure times carefully to ensure accurate sample collection. Surface testing requires gentle swabbing of suspected mold growth. Package your samples securely using the included materials and ship them using the express label provided. Expect results within 5-7 business days.
Pros
- Faster results than typical lab-analyzed kits
- Six tests cover essential testing needs
- Professional laboratory verification
- Reliable and accurate findings
- Clear, actionable reports
- Free laboratory fees included
- Priority processing speeds diagnosis
- Excellent customer support
Cons
- Fewer tests than larger kits
- Higher cost per test
- Still requires waiting for lab results
- May need additional tests for large properties
Best For
This kit works best when you need professional results quickly. The express laboratory processing helps you make timely decisions about remediation. It suits situations where you cannot wait extended periods for standard laboratory analysis.
5. Essential 6-Test Starter Kit for Basic Home Screening
This six-test starter kit provides essential mold detection capabilities at an entry-level price point. It covers fundamental testing needs for homeowners who want basic screening without extensive analysis. The kit focuses on simplicity and accessibility.
Product Description
The essential testing kit strips away complexity while maintaining testing effectiveness. It includes six straightforward tests that anyone can perform regardless of experience level. The detailed identification guide walks you through the entire process from sample collection to result interpretation.
Key Features
- Six individual test plates
- Simplified testing procedures
- HVAC system compatibility
- Surface and air testing options
- Comprehensive identification guide
- Visual result indicators
- Budget-friendly pricing
- Black mold detection capability
- Air quality testing components
How to Use
Open test plates in your selected locations, timing exposure according to the simple chart provided. The kit includes clear markers to help you label each test location. After exposure, seal plates and store them at room temperature away from direct sunlight. Review results after 48 hours using the identification guide to match visible growth patterns.
Pros
- Affordable entry point for mold testing
- Six tests handle basic screening needs
- Extremely simple to use
- No technical knowledge required
- Quick results timeline
- Comprehensive identification guide
- Good value for the price
- Reliable performance
Cons
- Limited to six tests only
- Basic analysis capabilities
- No laboratory verification
- Less detailed than premium kits
- May require additional kits for complete coverage
Best For
First-time users and budget-conscious homeowners benefit most from this kit. It provides an affordable way to screen your home for mold issues. The kit works well for routine checks or initial investigations before investing in more comprehensive testing.
Factors to Consider When Buying a Mold Test Kit
Number of Tests Included
The quantity of tests determines how thoroughly you can assess your property. Larger homes with multiple levels need more tests to achieve complete coverage. Consider testing basements, attics, bathrooms, kitchens, and any rooms with water damage history.
Single-test kits might suffice for small apartments or targeted investigations. However, mold often grows in multiple locations simultaneously. Having extra tests allows you to monitor different areas or track changes over time. Some kits offer better value by including more tests at slightly higher price points.
Testing Method and Analysis Type
Self-analyzing kits provide immediate visual results but limited species identification. You observe mold growth patterns and compare them against reference guides. This approach works well for general presence detection but may not identify dangerous mold varieties accurately.
Laboratory-analyzed kits send your samples to professional facilities equipped with advanced testing equipment. Technicians use microscopy and culturing methods to identify specific mold species and measure concentration levels. Lab reports provide detailed information about health risks and recommended actions.
Some kits offer hybrid approaches, giving you preliminary results at home while also providing laboratory verification. These combination kits balance speed with accuracy, though they typically cost more than basic options.
HVAC System Testing Capability
Your heating and cooling system can circulate mold spores throughout your entire home. HVAC testing helps you identify whether your ventilation system contributes to mold problems. Kits designed for HVAC testing include components that attach to vents or collect air samples during system operation.
Regular HVAC testing prevents widespread mold distribution. Clean ducts and filters reduce mold transmission between rooms. If tests reveal HVAC contamination, you can address the issue before it affects your entire living space.
Identification Guide Quality
Clear, detailed identification guides help you interpret your results accurately. Look for guides with color photographs showing various mold species at different growth stages. Text descriptions should explain health implications and recommended next steps for each mold type.
Some guides include troubleshooting sections that help you understand false positives or unusual growth patterns. The best guides explain how environmental factors affect test results. User-friendly guides reduce confusion and help you make informed decisions about remediation needs.
Surface and Air Testing Options
Comprehensive kits test both surfaces and air quality. Surface testing identifies visible or suspected mold growth on walls, ceilings, and other materials. Air testing detects airborne spore concentrations that may not produce visible growth.
Air testing proves especially valuable because mold spores float throughout your home. You might not see mold growth but still breathe contaminated air. Surface testing confirms active colonies that shed spores continuously. Having both testing options provides a complete picture of your mold situation.
Result Turnaround Time
Self-analysis kits typically show results within 48-72 hours. You simply observe the collection plates for visible growth. Fast results help you make quick decisions about living arrangements or remediation priorities.
Laboratory-analyzed kits require 1-2 weeks for complete results. Samples must travel to the lab, undergo analysis, and generate reports. Express laboratory services reduce this timeline to approximately one week. Consider your timeline needs when selecting between self-analysis and laboratory testing options.
Cost and Value Comparison
Basic self-testing kits start around $10-15 per test. Laboratory-analyzed kits range from $30-50 per test including analysis fees. Some kits include multiple tests at discounted rates, improving overall value.
Calculate the total cost including shipping, analysis fees, and any additional supplies needed. Free laboratory analysis adds significant value to kits that include this service. Consider the cost of professional inspection services, which often exceed $300-500, to appreciate the value of home testing kits.
Accuracy and Reliability
Look for kits that use established testing methods accepted by environmental professionals. Read customer reviews to understand real-world accuracy rates. Some manufacturers provide accuracy statistics based on comparison studies with professional testing services.
Kit reliability depends on proper storage, handling, and usage following instructions precisely. High-quality kits include freshness indicators or expiration dates. Reliable brands offer customer support to help troubleshoot concerns about result accuracy.
How to Get the Most Accurate Test Results
Start by identifying the most likely problem areas in your home. Basements, bathrooms, kitchens, and any spaces with water damage history require priority testing. Look for visible signs like discoloration, peeling paint, or warped materials that indicate moisture problems.
Test during typical living conditions rather than after opening windows or running fans. Normal conditions provide more representative results of your daily exposure levels. Avoid testing during unusually dry periods or immediately after heavy cleaning that might temporarily reduce mold levels.
Follow timing instructions precisely. Exposing collection plates too long or too short affects result accuracy. Use a timer to ensure consistent exposure periods across all test locations. For air testing, place plates at breathing height rather than on floors or high shelves.
Handle test plates carefully to avoid contamination from your hands or other surfaces. Keep plates sealed until you reach your testing location. After exposure, reseal plates immediately using the provided covers. Contaminated samples produce false positives that waste time and money.
Store incubating samples in consistent conditions away from extreme temperatures, direct sunlight, or excessive humidity. Inconsistent storage conditions affect growth patterns and may prevent mold colonies from developing properly. Room temperature closets or cabinets typically work well for incubation.
Take photographs of your test results for documentation purposes. Photos help you track changes over time or provide evidence to professionals if you seek additional consultation. Date your photos and note the test location for future reference.
Common Testing Mistakes to Avoid
Opening test plates in windy conditions or near fans disperses mold spores unnaturally. Calm air provides more accurate concentration measurements. Close windows and turn off fans before exposing collection plates. Wait at least 30 minutes after adjusting ventilation before beginning tests.
Testing only obvious problem areas misses hidden mold colonies. Mold grows behind walls, under carpets, and in other concealed spaces. Include apparently clean areas in your testing plan to catch problems before they become visible. HVAC systems especially require testing even when they appear clean.
Misinterpreting results causes unnecessary panic or dangerous complacency. Small amounts of mold growth are normal in most homes. Compare your results carefully against the identification guide before drawing conclusions. When in doubt, consult with professionals or consider laboratory analysis for verification.
Ignoring control samples leads to inaccurate conclusions. Some kits recommend exposing one plate outdoors to establish baseline spore levels. Comparing indoor results to outdoor controls helps you determine whether indoor levels exceed normal environmental concentrations.
Testing immediately after remediation may show residual spores that do not indicate ongoing growth. Wait at least two weeks after cleaning before testing to allow conditions to stabilize. Repeated testing over several weeks confirms whether remediation successfully eliminated the problem.
Failing to test after water damage or flooding invites hidden mold growth. Mold can establish colonies within 24-48 hours of water exposure. Test promptly after any water incident, then retest periodically to ensure mold has not developed during the drying process.
Understanding Your Test Results
Mold presence does not automatically indicate a health emergency. Small amounts of mold exist in virtually all indoor environments. Focus on whether your indoor mold levels significantly exceed outdoor concentrations. Excessive growth or specific dangerous species require immediate attention.
Different colors and textures indicate different mold species. Black or dark green growth suggests potentially harmful varieties like Stachybotrys chartarum, commonly called black mold. White or gray growth may represent Aspergillus or Penicillium species. Yellow or pink growth indicates different organisms that may or may not pose health risks.
Heavy growth covering most of the collection plate suggests serious contamination requiring professional remediation. Light growth with just a few small colonies indicates manageable levels that you might address through cleaning and improved ventilation. Use the density of growth as a general indicator of problem severity.
Laboratory reports provide species identification and concentration measurements. Reports typically classify results as low, moderate, or high concentrations. Low levels may require only improved ventilation. High levels necessitate professional remediation services. Moderate levels might respond to thorough cleaning combined with moisture control measures.
Some reports identify allergenic, pathogenic, or toxigenic mold varieties. Allergenic molds trigger allergic reactions in sensitive individuals. Pathogenic molds can cause infections, particularly in people with weakened immune systems. Toxigenic molds produce harmful chemicals called mycotoxins that pose health risks to everyone.
When to Call Professional Remediation Services
Extensive visible mold growth covering large surface areas exceeds DIY cleaning capabilities. Professional services have specialized equipment and expertise for safe, complete mold removal. They address hidden growth behind walls and in structural materials that homeowners cannot access safely.
Test results showing toxic mold species like Stachybotrys chartarum require professional intervention. These molds produce dangerous mycotoxins that can cause serious health effects. Attempting to clean toxic mold yourself risks exposure to high toxin concentrations during the removal process.
Recurring mold growth despite repeated cleaning indicates underlying moisture problems. Professionals can identify and fix the root causes of persistent mold issues. They have moisture meters, thermal imaging cameras, and other diagnostic tools to locate hidden water sources.
Health symptoms that correlate with time spent at home suggest serious mold exposure. Persistent respiratory issues, frequent headaches, or allergic reactions that improve when you leave home warrant professional investigation. Children, elderly residents, or anyone with compromised immunity should not remain in seriously contaminated environments.
Structural damage accompanying mold growth requires specialized assessment. Mold can weaken wood framing, drywall, and other building materials. Professionals evaluate whether materials need replacement or can be salvaged through proper treatment. They ensure your home remains structurally sound after remediation.
Preventing Future Mold Growth
Control moisture levels throughout your home. Keep indoor humidity below 50% using dehumidifiers in damp areas. Use exhaust fans in bathrooms and kitchens to remove moisture-laden air. Vent clothes dryers outside rather than into interior spaces.
Fix water leaks promptly. Dripping pipes, leaking roofs, and faulty appliances create ideal conditions for mold growth. Inspect your home regularly for signs of water damage. Address even small leaks before they cause extensive moisture problems.
Improve ventilation in problem areas. Open windows periodically to exchange stale indoor air with fresh outdoor air. Ensure your HVAC system circulates air effectively throughout your home. Consider installing additional ventilation in basement areas prone to dampness.
Clean and maintain HVAC systems regularly. Change filters according to manufacturer recommendations. Schedule professional duct cleaning every few years to remove accumulated dust and debris. Clean supply and return vents to prevent spore distribution.
Use mold-resistant materials during renovations. Mold-resistant drywall, paint, and insulation help prevent growth in moisture-prone areas. These products contain antimicrobial additives that inhibit mold colonization. Install them in bathrooms, basements, and other high-risk locations.
Address condensation problems on windows, pipes, and walls. Condensation indicates high humidity or inadequate insulation. Improve insulation on cold surfaces where moisture condenses. Use moisture-resistant window treatments that allow air circulation.
The Science Behind Mold Testing
Mold reproduces through microscopic spores that float through air. These spores land on suitable surfaces and germinate when conditions support growth. Temperature, moisture, and nutrient availability determine whether spores develop into visible colonies.
Collection plates contain nutrient media that supports mold growth. When spores land on the medium, they absorb nutrients and begin reproducing. Visible colonies appear after 24-48 hours as spores multiply into millions of cells. Each visible colony started from a single spore or cluster of spores.
Different mold species grow at different rates and produce characteristic appearances. Color, texture, and growth patterns help identify mold types. Laboratory identification uses microscopic examination of spore structures. Technicians may also perform DNA analysis for precise species identification.
Mold concentrations are measured in spores per cubic meter of air or colony-forming units on surfaces. These measurements help evaluate whether indoor levels exceed normal outdoor concentrations. Elevated indoor levels indicate active growth within your home requiring attention.
Environmental factors affect test accuracy. Temperature, humidity, and air movement influence how many spores land on collection plates during exposure. Consistent testing conditions improve result reliability. Multiple tests from the same location provide more accurate assessment than single samples.
Health Implications of Different Mold Types
Stachybotrys chartarum, known as black mold, produces trichothecene mycotoxins that can affect the nervous system, immune system, and respiratory system. Exposure causes symptoms ranging from headaches and fatigue to serious respiratory distress. Infants, elderly individuals, and immunocompromised people face the greatest risks.
Aspergillus species commonly grow indoors and produce various health effects depending on the specific species. Some cause allergic reactions while others can cause infections in people with weakened immunity. Aspergillus fumigatus can colonize lungs in susceptible individuals, creating serious medical complications.
Penicillium molds trigger allergic reactions and asthma attacks in sensitive people. While some Penicillium species help produce antibiotics, indoor varieties contribute to poor air quality. They grow on water-damaged materials and produce musty odors characteristic of moldy environments.
Cladosporium appears as black or olive-green growth on various surfaces. It typically causes allergic reactions rather than infections. People with mold allergies often react strongly to Cladosporium exposure. The mold spreads easily through air, affecting entire homes when present in significant quantities.
Alternaria commonly grows in damp indoor areas. It causes allergic reactions and can trigger severe asthma episodes. People with existing respiratory conditions are particularly vulnerable. The mold appears as dark green or brown velvety growth on various materials.
Testing After Water Damage or Flooding
Begin testing within 24-48 hours after water exposure. This timeline allows you to catch mold growth in early stages when remediation remains straightforward. Waiting longer gives mold time to establish extensive colonies requiring professional removal.
Test multiple locations throughout affected areas. Water damage often spreads beyond obviously wet zones. Check adjacent rooms, floors above water incidents, and spaces connected to plumbing systems. Hidden moisture behind walls can cause mold growth you cannot see.
Document conditions before and after water events. Take photographs of wet areas and test results. Record humidity readings and moisture meter data if available. This documentation helps you track remediation progress and provides evidence for insurance claims if needed.
Retest periodically during the drying process. Initial tests may show no growth because mold has not had time to develop. Follow-up testing after one week and two weeks confirms whether drying procedures successfully prevented mold establishment.
Continue monitoring for several weeks after materials appear dry. Residual moisture hidden in walls, floors, or insulation can support mold growth even after visible surfaces dry. Extended monitoring ensures problems do not develop after you think the issue is resolved.
Seasonal Testing Recommendations
Test during spring when increasing temperatures and humidity create ideal mold growth conditions. Winter moisture accumulated in walls and insulation begins evaporating as temperatures rise. This moisture release can trigger mold growth that was dormant during cold months.
Summer testing helps you monitor air conditioning systems for mold contamination. AC units generate condensation that can support mold growth in ductwork. High summer humidity also increases overall mold risk throughout your home.
Fall testing prepares you for winter when homes remain closed with limited ventilation. Identifying problems before winter allows you to address them before cold weather limits your remediation options. Fall is also when many people notice musty odors as heating systems activate.
Winter testing may show lower results because cold temperatures slow mold growth. However, winter testing reveals problems that persist even in unfavorable conditions. These serious infestations require attention regardless of seasonal variations.
Test after seasonal events that affect your home. Heavy spring rains, summer humidity, or winter ice dams can create conditions supporting mold growth. Test following these events rather than waiting for symptoms to appear.
Legal and Real Estate Considerations
Home buyers should test for mold before finalizing purchases. Mold problems can require expensive remediation that affects property values. Pre-purchase testing helps you negotiate repairs or price adjustments. Some states require sellers to disclose known mold issues.
Landlords should test rental properties regularly to protect tenants and avoid liability. Mold-related health issues can result in legal action against property owners. Regular testing demonstrates due diligence in maintaining safe living conditions. Document all testing results and remediation efforts.
Home sellers benefit from testing before listing properties. Discovering mold during your own testing gives you control over remediation timing and costs. Buyers who discover mold during inspections may withdraw offers or demand significant concessions. Proactive testing helps you present properties in the best condition.
Insurance claims for water damage often require mold testing documentation. Test promptly after incidents to establish baseline conditions. Follow-up testing proves whether remediation successfully addressed mold growth. Insurance companies may require professional testing, but home test results provide supporting evidence.
Environmental Impact and Safe Disposal
Most home testing kits use minimal plastic packaging and non-toxic materials. Collection media contains nutrients like those found in common foods. Exposed plates can typically be disposed of in household trash after sealing them in plastic bags.
Avoid releasing mold samples into your environment. Keep used test plates sealed to prevent spore dispersal during disposal. Place sealed plates in trash bags before discarding. This prevents spores from escaping and potentially establishing new colonies.
Some municipalities accept testing materials in regular trash while others recommend special handling for biological materials. Check local regulations for proper disposal procedures. When in doubt, seal materials thoroughly and dispose of them in household trash.
Laboratory-analyzed kits include prepaid return shipping so labs handle sample disposal appropriately. Labs follow strict protocols for biological material disposal. This eliminates concerns about proper handling of tested samples.
Cost Analysis: DIY Testing vs Professional Inspection
Professional mold inspections typically cost between $300-$800 depending on home size and inspection scope. Inspectors use advanced equipment like moisture meters, thermal imaging, and air quality monitors. They provide comprehensive reports but represent a significant investment.
Home testing kits range from $40-150 for multi-test packages. Laboratory analysis adds $30-50 per sample if not included. Even with lab fees, DIY testing costs substantially less than professional services. Multiple DIY testing sessions still cost less than a single professional inspection.
DIY testing provides sufficient information for most homeowners. You can identify problem areas, track mold levels, and verify remediation success. Professional inspection becomes necessary only when dealing with extensive contamination, toxic mold species, or situations requiring official documentation.
Consider hybrid approaches for maximum value. Use DIY kits for initial screening and monitoring. Call professionals when tests reveal serious problems requiring expert intervention. This strategy minimizes costs while ensuring you get professional help when truly needed.
Technology and Innovation in Home Mold Testing
Newer testing kits incorporate smartphone integration. Some manufacturers offer apps that help you photograph results, track multiple tests, and receive interpretation guidance. These digital tools simplify the testing process and improve result documentation.
Improved collection media captures more spores in shorter exposure times. Advanced nutrient formulations support faster colony development. These improvements deliver results more quickly while maintaining accuracy.
DNA-based identification methods are becoming more accessible for home testing. Some kits now offer PCR analysis that identifies mold species with high precision. These advanced tests cost more but provide laboratory-quality results.
Real-time mold monitors provide continuous air quality data. These electronic devices measure airborne mold spore concentrations automatically. They alert you when levels rise above safe thresholds. While more expensive than traditional kits, they offer ongoing monitoring without repeated testing.
Making Your Final Decision
Consider your specific needs and circumstances when selecting a mold test kit. Apartment renters might need only basic screening kits with a few tests. Homeowners should invest in comprehensive kits with multiple tests for thorough property assessment.
People with health concerns should prioritize laboratory-analyzed kits that identify specific mold species. Knowing exactly which molds are present helps doctors provide appropriate treatment. It also guides remediation priorities based on health risk levels.
Budget considerations matter, but cheap kits may waste money if they provide inadequate information. Investing in a quality kit with sufficient tests saves money compared to purchasing multiple insufficient kits. Laboratory analysis adds cost but provides valuable peace of mind.
Time sensitivity affects which kit suits your situation. Self-analysis kits work best when you need quick answers. Laboratory kits serve situations where accuracy matters more than speed. Express laboratory services split the difference for moderate urgency situations.
Conclusion
Mold contamination threatens both your health and your property value. Regular testing helps you detect problems before they require expensive remediation. The kits reviewed here offer reliable, affordable options for protecting your home environment.
The 12-test kit provides exceptional coverage for thorough home assessment. The 8-test kit with free lab analysis balances DIY convenience with professional verification. The 7-test system offers solid middle-ground performance at reasonable cost. The 6-test kit with express lab service delivers fast professional results. The essential 6-test starter kit provides budget-friendly basic screening.
Each kit serves different needs based on home size, budget, and desired analysis depth. Select the option that matches your specific situation. Remember that any testing is better than ignoring potential mold problems. Take action now to protect your family’s health and preserve your property investment.
Regular testing creates a baseline for your home’s normal mold levels. Periodic follow-up testing reveals changes that indicate developing problems. This proactive approach prevents small issues from becoming major health hazards or expensive remediation projects.
Your indoor air quality directly affects your quality of life. Don’t wait for visible mold growth or health symptoms to appear before taking action. Invest in a quality testing kit and gain valuable peace of mind about your living environment. The small investment in testing can save thousands in remediation costs and protect your family’s wellbeing.

Hi, I’m Mary, the founder of Homygear.com. I’m passionate about creating a comfortable, smart, and beautiful home. I share practical insights and real-world experience on home gear that makes everyday life easier. Behind the scenes, my dedicated research team studies products in depth, and our writers craft honest reviews using trusted, authentic sources—so you can choose home gear with confidence.